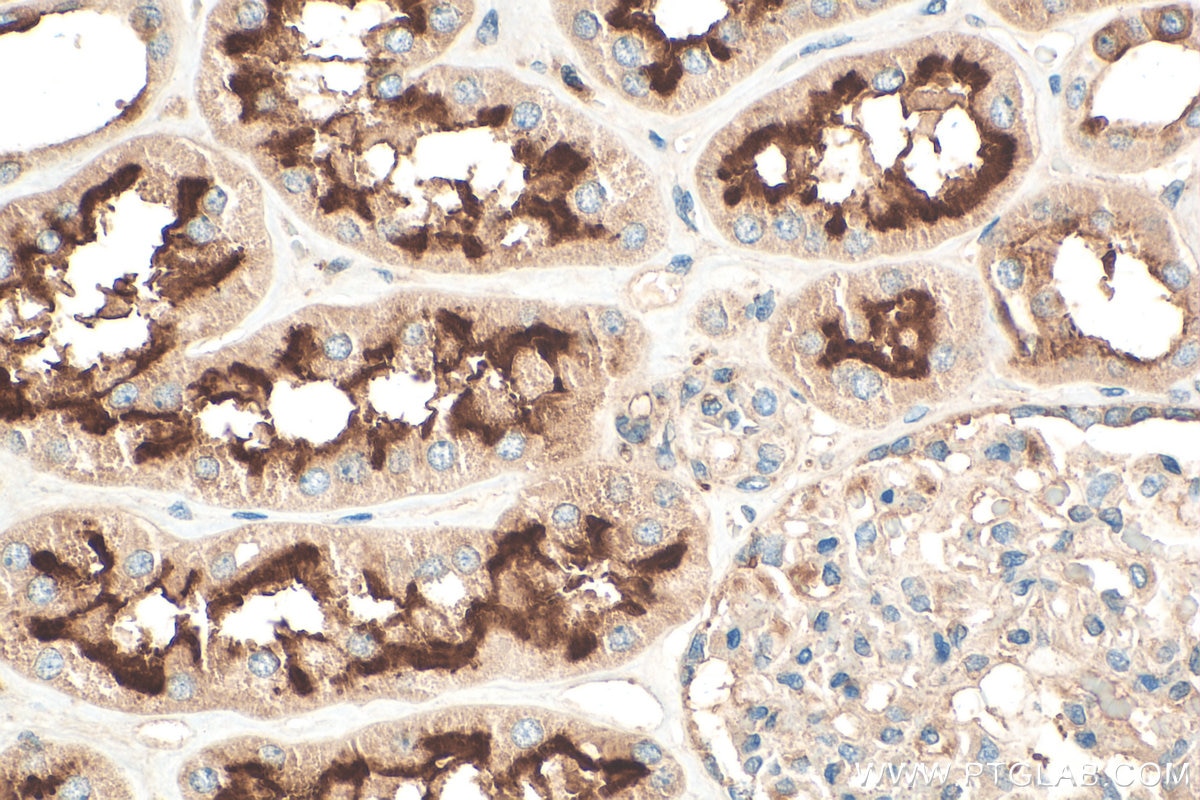
Immunohistochemistry (IHC) staining of human kidney tissue using ATP6V0D1 Polyclonal antibody (18274-1-AP)
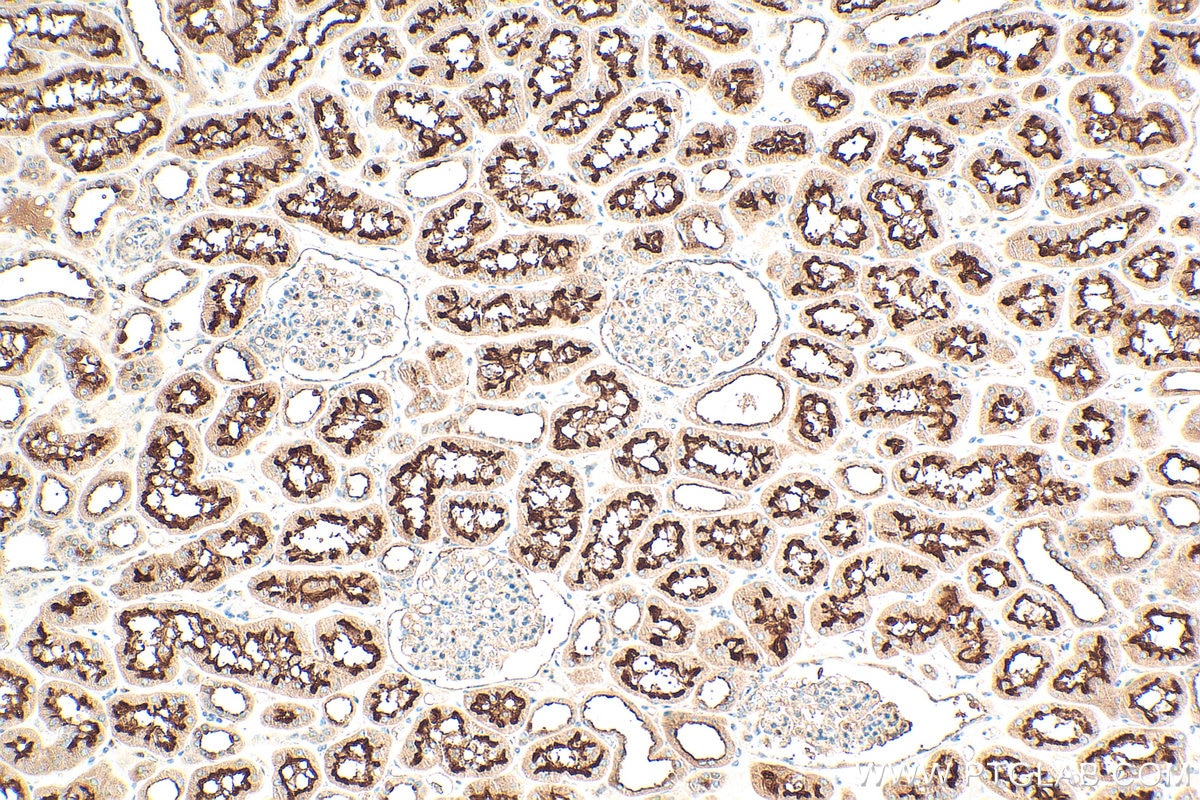
Immunohistochemistry (IHC) staining of human kidney tissue using ATP6V0D1 Polyclonal antibody (18274-1-AP)

Tested Applications
| Positive WB detected in | HEK-293 cells, human placenta tissue, HeLa cells, mouse kidney tissue, mouse testis tissue |
| Positive IP detected in | mouse testis tissue |
| Positive IHC detected in | mouse kidney tissue, human kidney tissue Note: suggested antigen retrieval with TE buffer pH 9.0; (*) Alternatively, antigen retrieval may be performed with citrate buffer pH 6.0 |
| Positive IF/ICC detected in | HeLa cells |
Recommended dilution
| Application | Dilution |
|---|---|
| Western Blot (WB) | WB : 1:2000-1:10000 |
| Immunoprecipitation (IP) | IP : 0.5-4.0 ug for 1.0-3.0 mg of total protein lysate |
| Immunohistochemistry (IHC) | IHC : 1:50-1:500 |
| Immunofluorescence (IF)/ICC | IF/ICC : 1:50-1:500 |
| It is recommended that this reagent should be titrated in each testing system to obtain optimal results. | |
| Sample-dependent, Check data in validation data gallery. | |
Published Applications
| KD/KO | See 1 publications below |
| WB | See 23 publications below |
| IHC | See 1 publications below |
| IF | See 7 publications below |
| IP | See 2 publications below |
Product Information
18274-1-AP targets ATP6V0D1 in WB, IHC, IF/ICC, IP, ELISA applications and shows reactivity with human, mouse, rat samples.
| Tested Reactivity | human, mouse, rat |
| Cited Reactivity | human, mouse, rat |
| Host / Isotype | Rabbit / IgG |
| Class | Polyclonal |
| Type | Antibody |
| Immunogen |
CatNo: Ag13002 Product name: Recombinant human ATP6V0D1 protein Source: e coli.-derived, PGEX-4T Tag: GST Domain: 1-351 aa of BC008861 Sequence: MSFFPELYFNVDNGYLEGLVRGLKAGVLSQADYLNLVQCETLEDLKLHLQSTDYGNFLANEASPLTVSVIDDRLKEKMVVEFRHMRNHAYEPLASFLDFITYSYMIDNVILLITGTLHQRSIAELVPKCHPLGSFEQMEAVNIAQTPAELYNAILVDTPLAAFFQDCISEQDLDEMNIEIIRNTLYKAYLESFYKFCTLLGGTTADAMCPILEFEADRRAFIITINSFGTELSKEDRAKLFPHCGRLYPEGLAQLARADDYEQVKNVADYYPEYKLLFEGAGSNPGDKTLEDRFFEHEVKLNKLAFLNQFHFGVFYAFVKLKEQECRNIVWIAECIAQRHRAKIDNYIPIF Predict reactive species |
| Full Name | ATPase, H+ transporting, lysosomal 38kDa, V0 subunit d1 |
| Calculated Molecular Weight | 351 aa, 40 kDa |
| Observed Molecular Weight | 37-41 kDa |
| GenBank Accession Number | BC008861 |
| Gene Symbol | ATP6V0D1 |
| Gene ID (NCBI) | 9114 |
| RRID | AB_2258877 |
| Conjugate | Unconjugated |
| Form | Liquid |
| Purification Method | Antigen affinity purification |
| UNIPROT ID | P61421 |
| Storage Buffer | PBS with 0.02% sodium azide and 50% glycerol, pH 7.3. |
| Storage Conditions | Store at -20°C. Stable for one year after shipment. Aliquoting is unnecessary for -20oC storage. 20ul sizes contain 0.1% BSA. |
Background Information
ATP6V0D1(V-type proton ATPase subunit d 1) is also named as ATP6D, VPATPD and belongs to the V-ATPase V0D/AC39 subunit family.It is responsible for acidifying a variety of intracellular compartments in eukaryotic cells, thus providing most of the energy required for transport processes in the vacuolar system.
Protocols
| Product Specific Protocols | |
|---|---|
| IF protocol for ATP6V0D1 antibody 18274-1-AP | Download protocol |
| IHC protocol for ATP6V0D1 antibody 18274-1-AP | Download protocol |
| IP protocol for ATP6V0D1 antibody 18274-1-AP | Download protocol |
| WB protocol for ATP6V0D1 antibody 18274-1-AP | Download protocol |
| Standard Protocols | |
|---|---|
| Click here to view our Standard Protocols |
Publications
| Species | Application | Title |
|---|---|---|
Autophagy Follicular lymphoma-associated mutations in the V-ATPase chaperone VMA21 activate autophagy creating a targetable dependency | ||
Autophagy Disruption of the vacuolar-type H(+)-ATPase complex in liver causes MTORC1-independent accumulation of autophagic vacuoles and lysosomes. | ||
Cell Mol Life Sci The Ncoa7 locus regulates V-ATPase formation and function, neurodevelopment and behaviour. | ||
Cells A Role for the V0 Sector of the V-ATPase in Neuroexocytosis: Exogenous V0d Blocks Complexin and SNARE Interactions with V0c |
Reviews
The reviews below have been submitted by verified Proteintech customers who received an incentive for providing their feedback.
FH Zakia (Verified Customer) (05-22-2024) | we are using this for our lab, Works great,
 |